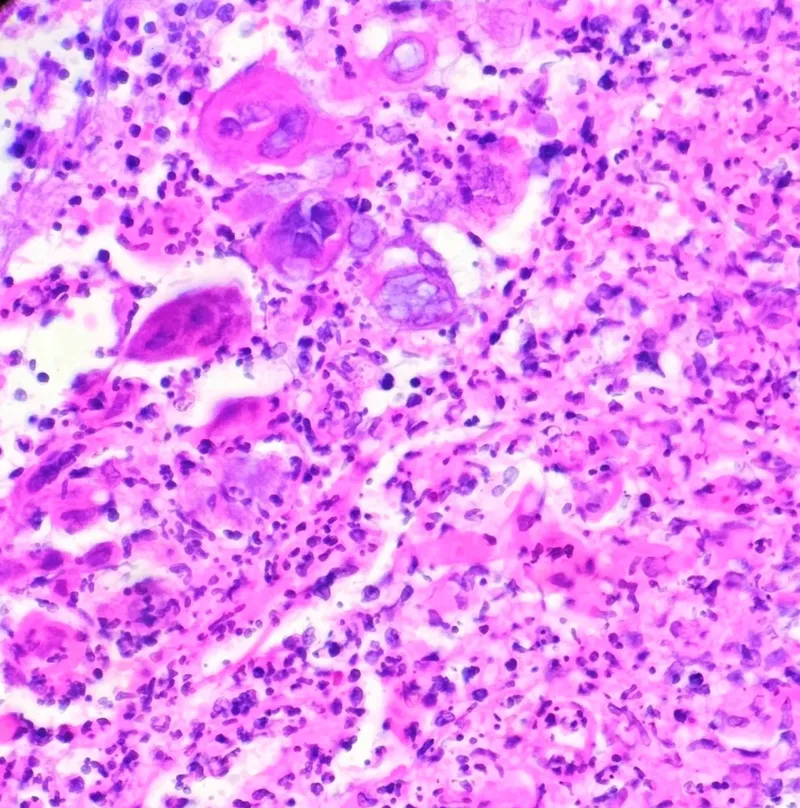
Comparative histopathology of viral versus bacterial skin infections

Enter your email to get your 85% OFF code and unlock the full NEET PG question bank on the app.
Viral skin infections transform your body's largest organ into a diagnostic canvas where herpes simplex clusters, varicella-zoster dermatomal bands, and molluscum umbilicated papules tell distinct clinical stories. You'll master the morphological patterns that separate benign self-limited eruptions from those demanding urgent antiviral intervention, build systematic frameworks for recognizing distribution patterns and temporal evolution, and develop the differential precision to distinguish viral mimics from bacterial, fungal, and inflammatory imposters. This lesson equips you with treatment algorithms that match therapeutic intensity to disease severity while integrating immunologic context, because recognizing when a simple vesicle signals systemic compromise separates competent from exceptional clinical judgment.

Viral skin infections follow predictable invasion patterns that determine clinical presentation and therapeutic response. The epidermis serves as the primary battleground, where viral tropism, host immunity, and tissue response create distinct morphological signatures.
DNA Viruses (Herpesviruses, Poxviruses, HPV)
RNA Viruses (Enteroviruses, Paramyxoviruses)
📌 Remember: DIVE for DNA virus characteristics - Deep tissue invasion, Incubation >7 days, Vesicular morphology, Established latency
The skin's antiviral defense operates through 3 integrated systems that determine infection severity and clinical course. Understanding these mechanisms predicts treatment response and complication risk.
| Defense System | Response Time | Effectiveness | Clinical Correlation | Failure Consequences |
|---|---|---|---|---|
| Innate Immunity | 0-4 hours | 60-70% | Initial viral clearance | Widespread dissemination |
| Cellular Immunity | 3-7 days | 85-95% | Lesion containment | Chronic/recurrent infection |
| Humoral Immunity | 7-14 days | 90-99% | Long-term protection | Reinfection susceptibility |
| Memory Response | 24-48 hours | >95% | Rapid viral clearance | Severe recurrent disease |
| Interferon System | 2-6 hours | 70-80% | Viral replication block | Extensive tissue damage |
💡 Master This: CD8+ T-cell dysfunction predicts severe HSV/VZV infections, while CD4+ deficiency correlates with persistent HPV and extensive molluscum contagiosum
The interferon cascade represents the skin's first-line antiviral response, activated within 2 hours of viral detection. Type I interferons (IFN-α/β) block viral replication in adjacent cells, creating protective zones around infection sites. Type II interferon (IFN-γ) enhances NK cell and macrophage antiviral activity, determining lesion resolution timeframes.
Connect viral invasion patterns through morphological recognition systems to understand diagnostic frameworks.
Viral skin lesions organize into 5 primary morphological patterns, each reflecting specific viral-host interactions and tissue responses. Mastering these patterns enables immediate diagnostic categorization and appropriate management selection.
Vesicular Pattern (HSV, VZV, Enterovirus)
Papular Pattern (HPV, Molluscum, Poxviruses)
📌 Remember: VESPA for vesicular virus features - Viral giant cells, Epidermal separation, Serous fluid, Painful lesions, Acute onset
Distinguishing morphologically similar viral infections requires systematic evaluation of 6 key parameters that provide diagnostic specificity >90%. These discriminators separate common mimics and guide targeted therapy.
| Morphological Feature | HSV | VZV | Coxsackie | Molluscum | HPV |
|---|---|---|---|---|---|
| Vesicle Grouping | Clustered | Linear/dermatomal | Scattered | N/A | N/A |
| Base Erythema | Intense | Moderate | Minimal | Absent | Variable |
| Pain/Pruritus | Severe pain | Severe pain | Mild | Asymptomatic | Mild pruritus |
| Distribution | Mucocutaneous | Unilateral | Acral | Flexural | Pressure points |
| Evolution Time | 2-7 days | 7-14 days | 5-10 days | 6-12 months | Months-years |
| Recurrence | Common | Rare | None | Rare | Common |
💡 Master This: Koebner phenomenon (lesions at trauma sites) occurs in HPV (70% of cases) and molluscum (40% of cases) but never in HSV/VZV infections
The temporal evolution pattern provides crucial diagnostic information, where acute vesicular eruptions (<48 hours) suggest herpesvirus infections, while gradual papular development (weeks to months) indicates DNA tumor viruses like HPV or molluscum.
Connect morphological patterns through clinical recognition frameworks to understand systematic diagnostic approaches.
The VIRAL assessment framework provides comprehensive evaluation of suspected viral skin infections, ensuring systematic consideration of all diagnostic elements within 2-3 minutes of clinical examination.
Vesicular vs. Verrucous morphology assessment
Incubation and Immune status evaluation
Recurrence and Risk factor analysis
📌 Remember: RAPID for emergency viral recognition - Rash distribution, Acute vs chronic, Pain assessment, Immune status, Dermatomal pattern
Experienced clinicians use rapid discriminators that provide immediate diagnostic direction based on single clinical features with high predictive value. These shortcuts enable efficient triage and appropriate urgency assignment.
"See This, Think That" Recognition Patterns
Distribution Pattern Diagnostic Clues
⭐ Clinical Pearl: Pain preceding rash by 24-72 hours indicates VZV with >90% sensitivity, while simultaneous pain and vesicles suggest HSV
💡 Master This: Immunocompromised patients show atypical distributions in 40% of cases, requiring broader differential consideration and lower threshold for antiviral therapy
The temporal relationship between symptoms and lesions provides crucial diagnostic information: HSV typically shows simultaneous onset, VZV demonstrates prodromal pain, and Coxsackie presents with systemic symptoms preceding skin lesions by 1-2 days.

Connect clinical recognition patterns through systematic differential frameworks to understand diagnostic precision.
The systematic comparison of viral infections against primary mimics enables rapid diagnostic refinement and appropriate therapeutic selection. This matrix provides evidence-based discriminators with sensitivity and specificity data.
| Feature | Viral | Bacterial | Fungal | Inflammatory | Diagnostic Weight |
|---|---|---|---|---|---|
| Onset Speed | 2-7 days | Hours-2 days | Weeks-months | Days-weeks | High |
| Fever Pattern | Low-grade | High-grade | Absent | Variable | Moderate |
| Pain Quality | Burning/tingling | Throbbing | Pruritic | Variable | High |
| Lesion Border | Well-defined | Irregular | Scaly | Geometric | Moderate |
| Pus Formation | Rare | Common | Rare | Never | High |
| Response to Antibiotics | None | Rapid | None | None | Very High |
| Viral Culture | Positive | Negative | Negative | Negative | Definitive |
Vesicular lesions present the greatest diagnostic challenge in viral dermatology, where HSV, VZV, and enterovirus infections require precise differentiation for appropriate antiviral therapy. Misdiagnosis rates reach 25-30% without systematic evaluation.
HSV vs. VZV Discrimination
Viral vs. Bacterial Vesicles
⭐ Clinical Pearl: Tzanck smear showing multinucleated giant cells confirms herpesvirus infection with 80% sensitivity but cannot distinguish HSV from VZV
💡 Master This: PCR testing provides >95% sensitivity and >99% specificity for HSV/VZV differentiation, with results available within 24 hours in most laboratories
Papular viral lesions require differentiation from seborrheic keratoses, skin tags, and inflammatory papules. Chronic nature and specific morphological features guide systematic evaluation.
Molluscum vs. Other Papules
HPV Warts vs. Calluses
Connect differential frameworks through treatment algorithms to understand evidence-based therapeutic approaches.
The TREAT protocol provides comprehensive treatment planning for viral skin infections, ensuring systematic consideration of all therapeutic variables within evidence-based guidelines.
Type-specific Therapy selection
Risk stratification and Renal adjustment
Efficacy monitoring and Emergency recognition
📌 Remember: DOSE for antiviral dosing - Double for immunocompromised, Oral preferred, Start within 72 hours, Evaluate renal function
Antiviral therapy effectiveness depends on early initiation (<72 hours), appropriate dosing, and treatment duration. Evidence-based protocols provide optimal outcomes with minimal resistance development.
| Condition | First-Line Therapy | Dosing | Duration | Efficacy | Alternative |
|---|---|---|---|---|---|
| HSV Primary | Acyclovir | 400mg TID | 7-10 days | 85% reduction | Valacyclovir 1g BID |
| HSV Recurrent | Valacyclovir | 500mg BID | 3-5 days | 50% reduction | Famciclovir 125mg BID |
| VZV Zoster | Valacyclovir | 1g TID | 7 days | 70% pain reduction | Acyclovir 800mg 5x |
| VZV Varicella | Acyclovir | 20mg/kg QID | 5 days | 25% severity reduction | Valacyclovir (adults) |
| HPV Warts | Cryotherapy | -196°C 10-30sec | Q2-3 weeks | 60-80% clearance | Imiquimod 5% |
💡 Master This: Immunocompromised patients require IV acyclovir (10mg/kg q8h) for severe infections with >95% bioavailability compared to 15-30% oral absorption
Complex cases require specialized approaches that address treatment resistance, unusual presentations, and high-risk patients. Advanced protocols integrate newer antivirals and combination therapies.
Antiviral Resistance Management
Immunocompromised Protocols
Connect treatment algorithms through multi-system integration to understand comprehensive viral infection management.
Cutaneous viral infections serve as windows into systemic immune function, where skin manifestations predict overall viral control and immune competence. Understanding these relationships enables comprehensive patient assessment and proactive management.
Immune System Integration Patterns
Systemic Viral Load Correlations
📌 Remember: SYSTEM for viral systemic assessment - Skin severity, Yearly recurrence, Systemic symptoms, Timing patterns, Extracutaneous sites, Multiple viral types
Recent advances in viral pathogenesis understanding and therapeutic development are transforming clinical practice. Emerging research reveals novel therapeutic targets and precision medicine approaches.
| Research Area | Key Findings | Clinical Impact | Timeline | Success Rate |
|---|---|---|---|---|
| mRNA Vaccines | HSV-2 prevention | Phase 3 trials | 2025-2027 | 75% efficacy |
| CRISPR Therapy | Latent HSV elimination | Preclinical | 2028-2030 | 90% viral clearance |
| Immunomodulators | Enhanced viral clearance | Clinical use | Current | 60% improvement |
| Topical Antivirals | Novel delivery systems | FDA approval | 2024-2025 | 80% bioavailability |
| Viral Resistance | Resistance mechanisms | Diagnostic tests | Current | >95% detection |
💡 Master This: Combination antiviral therapy (acyclovir + helicase inhibitor) demonstrates synergistic effects with 10-fold increased viral suppression compared to monotherapy
Complex viral infections require coordinated care across multiple specialties, where dermatologists serve as central coordinators for comprehensive management. Integration protocols ensure optimal outcomes through systematic collaboration.
Multidisciplinary Care Pathways
Systematic Monitoring Protocols
Connect multi-system integration through rapid mastery frameworks to understand comprehensive clinical expertise.
Clinical mastery of viral skin infections requires immediate access to critical decision tools, quantitative thresholds, and systematic approaches that enable expert-level practice. The Clinical Arsenal provides rapid-reference frameworks for optimal patient outcomes.
Expert clinicians memorize key quantitative thresholds that drive immediate clinical decisions and optimize therapeutic outcomes. These critical numbers represent evidence-based benchmarks for superior practice.
Diagnostic Thresholds
Treatment Timing Thresholds
Severity Assessment Numbers
📌 Remember: MASTER numbers - Maximum 72-hour window, Antiviral >95% PCR, Severe >20 lesions, Threshold CD4 <200, Emergency IV therapy, Resistance >10 days
Emergency situations require systematic rapid assessment that provides diagnostic accuracy and treatment decisions within 60 seconds. This structured approach ensures comprehensive evaluation under time pressure.
| Assessment Step | Time | Key Questions | Decision Point |
|---|---|---|---|
| Visual Inspection | 10 seconds | Vesicular vs. papular? | Morphology category |
| Distribution Check | 10 seconds | Grouped, dermatomal, scattered? | Viral type hypothesis |
| History Rapid | 20 seconds | Onset, pain, recurrence? | Confirm/refute hypothesis |
| Risk Assessment | 10 seconds | Immunocompromised, pregnancy? | Treatment intensity |
| Decision | 10 seconds | Antiviral, supportive, referral? | Management plan |
💡 Master This: Pattern recognition mastery develops through systematic practice with >1000 cases, achieving expert-level accuracy within 2-3 years of focused training
The Clinical Mastery Arsenal transforms theoretical knowledge into practical expertise through systematic application of evidence-based protocols, quantitative thresholds, and rapid decision frameworks that optimize patient outcomes in viral skin infection management.
Signup to continue reading this lesson and unlimited access questions, flashcards, AI notes, and more
Have doubts about this lesson?
Ask Rezzy, your AI Study Partner, to explain anything you didn't understand
Get full Oncourse access with lessons, practice questions, flashcards and AI study tools.
Scan to download app